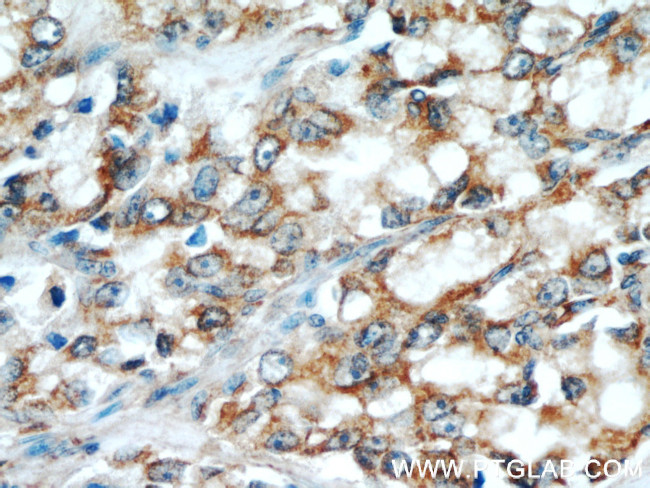
GRIM19 Antibody in Immunohistochemistry (Paraffin) (IHC (P))
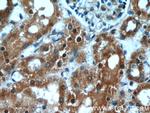
GRIM19 Antibody in Immunohistochemistry (Paraffin) (IHC (P))

Search
Proteintech
GRIM19 Polyclonal Antibody
{{$productOrderCtrl.translations['antibody.pdp.commerceCard.promotion.promotions']}}
{{$productOrderCtrl.translations['antibody.pdp.commerceCard.promotion.viewpromo']}}
{{$productOrderCtrl.translations['antibody.pdp.commerceCard.promotion.promocode']}}: {{promo.promoCode}} {{promo.promoTitle}} {{promo.promoDescription}}. {{$productOrderCtrl.translations['antibody.pdp.commerceCard.promotion.learnmore']}}
产品信息
10986-1-AP
种属反应
已发表种属
宿主/亚型
分类
类型
抗原
偶联物
形式
浓度
规格
纯化类型
保存液
内含物
保存条件
运输条件
产品详细信息
Immunogen sequence: MAASKVKQD MPPPGGYGPI DYKRNLPRRG LSGYSMLAIG IGTLIYGHWS IMKWNRERRR LQIEDFEARI ALLPLLQAET DRRTLQMLRE NLEEEAIIMK DVPDWKVGES VFHTTRWVPP LIGELYGLRT TEEALHASHG FMWYT (1-144 aa encoded by BC009189)
靶标信息
A novel gene associated with Retinoid-IFN-induced Mortality (GRIM) GRIM-19 gene was identified. Antisense expression of GRIM-19 confers a strong resistance against IFN/RA-induced death by reducing the intracellular levels of GRIM-19 protein. Overexpression of GRIM-19 enhances cell death in response to IFN/RA. GRIM-19 is primarily a nuclear protein whose expression is induced by the IFN/RA combination. These data indicate that GRIM-19 is a novel cell death-regulatory molecule.
仅用于科研。不用于诊断过程。未经明确授权不得转售。
生物信息学
蛋白别名: associated with retinoid-interferon induced mortality; Cell d; Cell death regulatory protein GRIM-19; cell death-regulatory protein GRIM19; CI-B16.6; complex I B16.6 subunit; Complex I-B16.6; FLJ58045; FLJ59191; gene associated with retinoic and IFN-induced mortality 19 protein; Gene associated with retinoic and interferon-induced mortality 19 protein; gene associated with retinoic-interferon-induced mortality 19 protein; genes associated with retinoid-IFN-induced mortality 19; GRIM-19; NADH dehydrogenase (ubiquinone) 1 alpha subcomplex, 13; NADH dehydrogenase [ubiquinone] 1 alpha subcomplex subunit 13; NADH-ubiquinone oxidoreductase B16.6 subunit; unnamed protein product
基因别名: 2700054G14Rik; AU022060; B16.6; CDA016; CGI-39; GRIM-19; GRIM19; MC1DN28; NDUFA13
UniProt ID: (Human) Q9P0J0, (Mouse) Q9ERS2
Entrez Gene ID: (Rat) 100911483, (Human) 51079, (Mouse) 67184